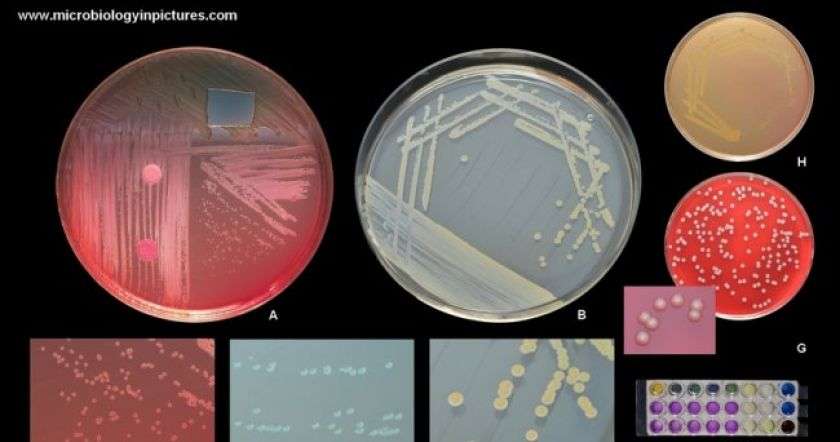

Աշխարհում վտանգավոր սուպերբակտերիա է տարածվում: Ինչպես հայտնում է Medical Express-ը, Stenotrophomonas maltophilia-ն վտանգավոր բակտերիա է, որը կայուն է հակաբիոտիկների նկատմամբ: Դրա շտամմները հանդիպում են մի քանի բնական եւ մարդու հետ կապված էկոհամակարգերում:
Երկար ժամանակ այդ բակտերիան համարվել է անվտանգ, սակայն այժմ դա ամենասարսափելի ներհիվանդանոցային պաթոգեններից է: Այն հատկապես վտանգ է ներկայացնում թույլ իմունտետ եւ թոքերի բորբոքային հիվանդություններ ունեցող պացիենտների համար:
Research Center Borstel Leibniz Lung Center-ի հղկողությամբ անցկացված հետազոտության շրջանակում պաթոգենի գենոմի անալիզ է անցկացվել, ինչը թույլ է տվել առանձնացնել տարածվածության տարբեր մակարդակներով ծագման 23 գիծ:
Մեկ կոնկրետ գիծը տարածված է ամբողջ աշխարհում եւ ունի մարդու հետ կապված շտամմերի բարձր մակարդակ:











